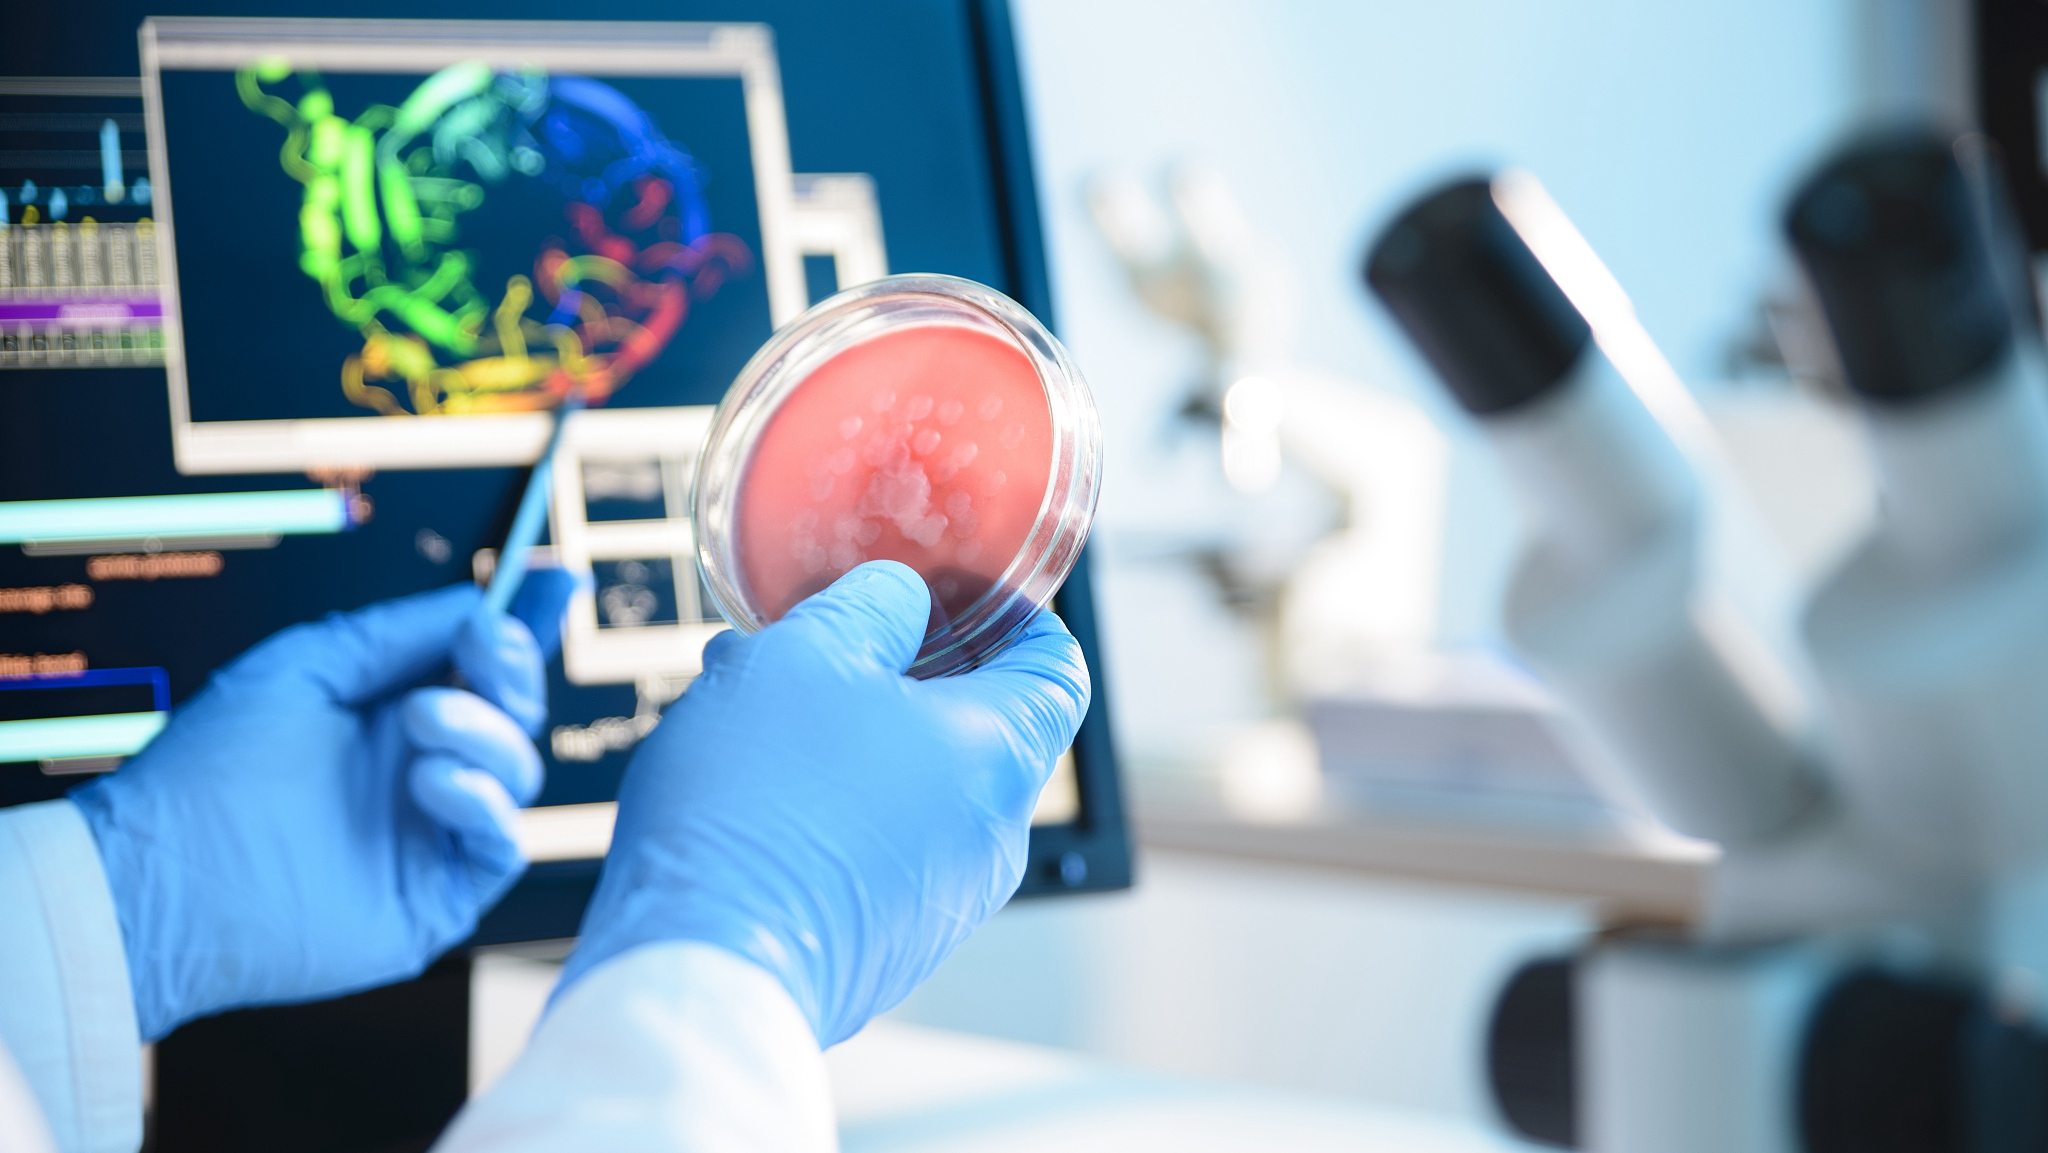

Disease
10:37, 14-Aug-2018
Disruption of nitrogen metabolism may lead to early detection of cancer
Updated
10:17, 17-Aug-2018
CGTN
An Israeli study said on Monday that the disruption of a cancer patient's nitrogen metabolism could lead to changes in the body fluids, which in turn contribute to the mutations in cancerous tissue.
The study, published in Cell by the researchers at the Weizmann Institute of Science, stressed that the findings may help the early cancer detection in the future and treatment prediction of immunotherapy.
These findings suggest that disruption of a cycle of urination in the liver and tumors produces nitric markers that may facilitate the early detection of cancer.
The scientists found that melanoma patients with a disruption in enzyme expression responded better to immunotherapy than patients without these disruptions.
Source(s): Xinhua News Agency

SITEMAP
Copyright © 2018 CGTN. Beijing ICP prepared NO.16065310-3
Copyright © 2018 CGTN. Beijing ICP prepared NO.16065310-3